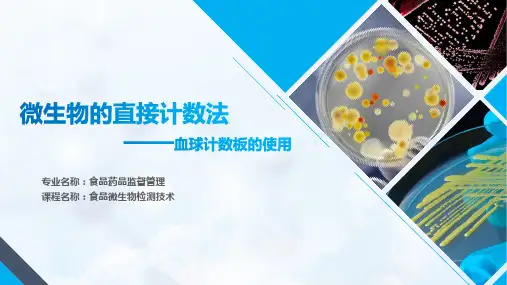

血细胞计数板的使用课件
- 格式:ppt
- 大小:350.00 KB
- 文档页数:10




血球计数板的构造和使用血球计数板是由一块比普通载玻片厚的特制玻片制成的.玻片中有四条下凹的槽,构成三个平台.中间的平台较宽,其中间又被一短横槽隔为两半,每半边上面,刻有一个方格网.方格网上刻有9个大方格,其中只有中间的一个大方格为计数室,供微生物计数用.这一大方格的长和宽各为1mm,深度为0.1mm,其体积为0.1mm3.计数室通常有两种规格.一种是大方格内分为16中格,每一中格又分为25小格;另一种是大方格内分为25中格,每一中格又分为16小格.但是不管计数室是哪一种构造;它们都有一个共同的特点,即每一大方格都是由16×25=25×16=400个小方格组成,见图.血球计数板的使用以计数酵母菌为例(1)用血球计数板计数酵母菌悬液的酵母菌个数.(2)样品稀释的目的是便于酵母菌悬液的计数,以每小方格内含有4-5个酵母细胞为宜,一般稀释10倍即可.(3)将血球计数板用擦镜纸擦净,在中央计数室上加盖专用的厚玻片.(4)将稀释后的酵母菌悬液,用吸管吸取一滴置于盖玻片的边缘,使菌液缓缓渗入,多余的菌液用吸水纸吸取,捎待片刻,使酵母菌全部沉降到血球计数室内.(5)计数时,如果使用16格×25格规格的计数室,要按对角线位,取左上,右上,左下,右下4个中格(即100个小格)的酵母菌数.如果规格为25格×16格的计数板,除了取其4个对角方位外,还需再数中央的一个中格(即80个小方格)的酵母菌数.(6)当遇到位于大格线上的酵母菌,一般只计数大方格的上方和右方线上的酵母细胞(或只计数下方和左方线上的酵母细胞).(7)对每个样品计数三次,取其平均值,按下列公式计算每1ml菌液中所含的酵母菌个数.3.计算公式(1)16格×25格的血球计数板计算公式:酵母细胞数/ml=100小格内酵母细胞个数/100×400×104×稀释倍数(2)25格x16格的血球计数板计算公式:酵母细胞数/ml=80小格内酵母细胞个数/80×400×104×稀释倍数4.血球计数板的清洁血球汁数板使用后,用自来水冲洗,切勿用硬物洗刷,洗后自行晾干或用吹风机吹干,或用95%的乙醇,无水乙醇,丙酮等有机溶剂脱水使其干燥.通过镜检观察每小格内是否残留菌体或其他沉淀物.若不干净,则必须重复清洗直到干净为止.。